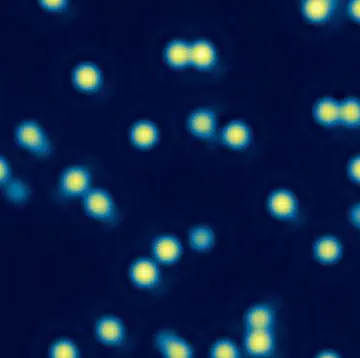
Quantum-gas microscopy with K<sup>40</sup>

Quantum gas microscopes


In our group we have two experiments in which we can observe and manipulate single ultracold atoms in an optical lattice, one using fermionic Potassium-40 atoms and one with bosonic Rubidium-87.
Ultracold atoms in optical lattices offer unique possibilities as quantum simulators for the study of many-body quantum systems, relevant for example to material science and other disciplines. To further enhance the capabilities of these systems, we use programmable static and dynamically varying light potentials. Our approach uses a spatial light modulator to create arbitrary potentials that project onto the atoms with sub-wavelength resolution using a high-resolution optical microscope. The same microscope setup enables us to detect the atoms in a two-dimensional optical lattice with single-lattice-site resolution (see the images of atomic clouds below).
We can use these potentials to alter the lattice geometry that the atoms experience. Recently we have studied incommensurate states in one dimension which we created by initializing a fixed number of atoms in between two movable barriers [Nat Commun 15, 474 (2024)]. In the future we want to study interesting many-body quantum phenomena in one and two dimensions using our bosons and fermions.
Update July 2024:
We are looking for a Postdoc to join our team. Please see here.
Research